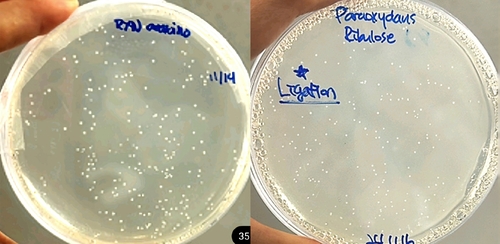

(서울=연합뉴스) 이재영 기자 = 과당을 알룰로스로 전환하는 미생물 균주를 찾아냈다고 국립낙동강생물자원관이 7일 밝혔다.
알룰로스는 설탕만큼 달지만, 열량은 10분의 1 수준이어서 최근 주목받는다.
현재 식품업체들은 대체로 알룰로스 생산력을 향상한 유전자 변형 미생물로 알룰로스를 생산한다. 자연 상태 미생물은 알룰로스를 효율적으로 생산하지 못하는 경우가 많아서다.
낙동강생물자원관이 찾아낸 '마이크로박테리움 아라비노갈락타놀리티쿰'과 '마이크로박테리움 파라옥시단스'종 미생물은 과당을 알룰로스로 효율적으로 전환했다.
이 미생물들에서 유래된 효소의 알룰로스 전환율은 식품공장에서 활용할 수 있는 수준이라고 자원관은 설명했다.
특히 마이크로박테리움 파라옥시단스에서 유래된 효소는 70도 이상 고온에서도 활성화됐다.
자원관은 이번 연구 관련 특허를 8∼9월 출원할 예정이다.
jylee24@yna.co.kr
(끝)
<저작권자(c) 연합뉴스, 무단 전재-재배포, AI 학습 및 활용 금지>
관련뉴스








